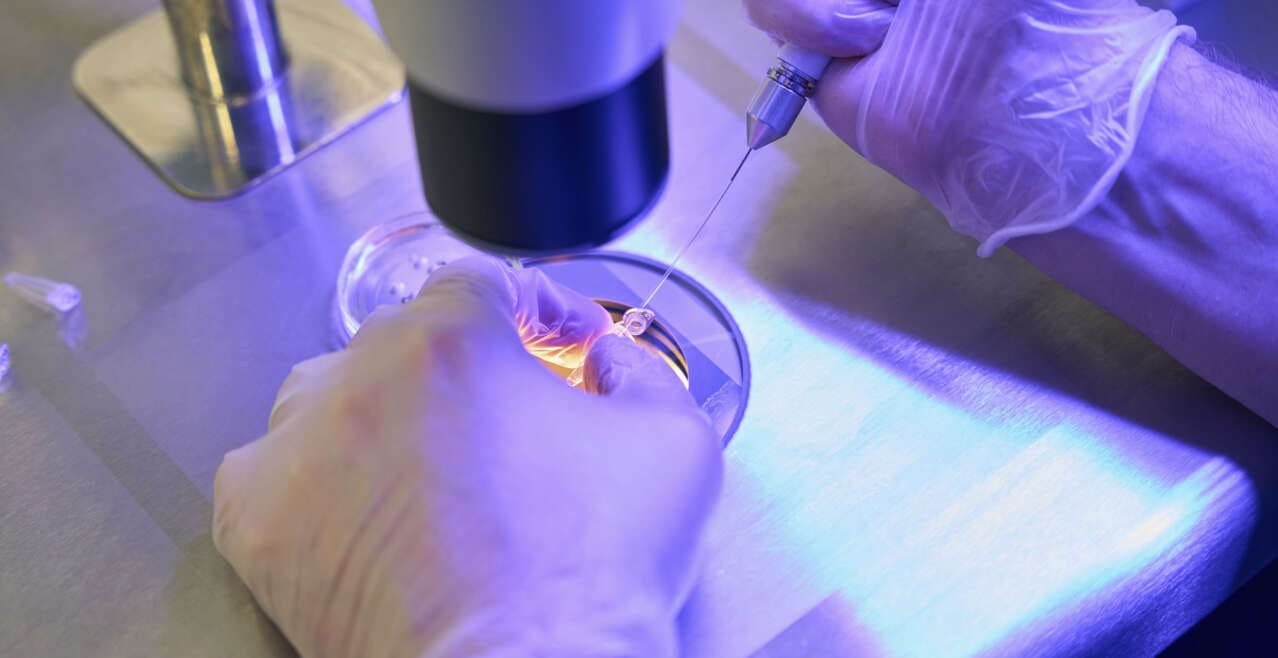
In Vitro Fertilization (IVF) with Egg Donation

IVF with Egg Donation
In Vitro Fertilization (IVF) with Egg Donation is an assisted reproductive treatment in which donated eggs from a woman are used to fertilize with the sperm of the recipient’s partner or a donor. This procedure is recommended for women who cannot produce viable eggs themselves due to health issues, advanced age, or genetic conditions.
During the treatment, donated eggs are fertilized in the laboratory through IVF, and the resulting embryos are transferred to the uterus of the recipient patient. IVF with Egg Donation offers a motherhood option to women who otherwise could not conceive naturally. It is an effective and safe solution for couples with fertility issues and can provide an opportunity to experience pregnancy and motherhood.